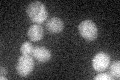
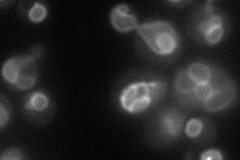
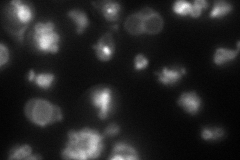
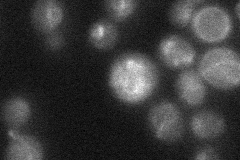
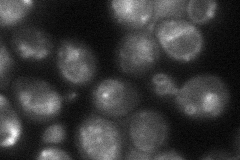
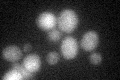

View description
Vacuolar transporter, exports large neutral amino acids from the vacuole; member of a family of seven S. cerevisiae genes (AVT1-7) related to vesicular GABA-glycine transporters
Localization:
Intensity:
Fold change:
Significance:
-
C’ GFP library in SD
below threshold19.84 -
N' NOP1pr-GFP in SD
vacuole membrane48.0321 -
N' TEF2pr-mCherry in SD
vacuole membrane73.7957 -
N' NATIVEpr-GFP in SD
vacuole membrane22.7064 -
N' TEF2pr-VC and Cyto-VN in SD
vacuole membrane40.4238 -
C’ GFP library in SD+DTT
cytosol17.830.89No -
C’ GFP library in SD+H2O2

cytosol17.420.87No -
C’ GFP library in Starvation Media

cytosol18.170.91No -
C’ GFP library on the background of Pup2-DaMP

below threshold -
C’ GFP library on the background of CCT mutant

below threshold16.12240.812509No
